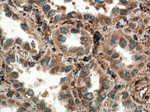
SEPT7 Antibody in Immunohistochemistry (Paraffin) (IHC (P))

Search
Proteintech
SEPT7 Polyclonal Antibody
{{$productOrderCtrl.translations['antibody.pdp.commerceCard.promotion.promotions']}}
{{$productOrderCtrl.translations['antibody.pdp.commerceCard.promotion.viewpromo']}}
{{$productOrderCtrl.translations['antibody.pdp.commerceCard.promotion.promocode']}}: {{promo.promoCode}} {{promo.promoTitle}} {{promo.promoDescription}}. {{$productOrderCtrl.translations['antibody.pdp.commerceCard.promotion.learnmore']}}
产品信息
13818-1-AP
种属反应
已发表种属
宿主/亚型
分类
类型
抗原
偶联物
形式
浓度
规格
纯化类型
保存液
内含物
保存条件
运输条件
产品详细信息
Immunogen sequence: VIDYIDSKF EDYLNAESRV NRRQMPDNRV QCCLYFIAPS GHGLKPLDIE FMKRLHEKVN IIPLIAKADT LTPEECQQFK KQIMKEIQEH KIKIYEFPET DDEEENKLVK KIKDRLPLAV VGSNTIIEVN GKRVRGRQYP WGVAEVENGE HCDFTILRNM LIRTHMQDLK DVTNNVHYEN YRSRKLAAVT YNGVDNNKNK GQLTKSPLAQ MEEERREHVA KMKKMEMEME QVFEMKVKEK VQKLKDSEAE LQRRHEQMKK NLEAQHKELE EKRRQFEDEK ANWEAQQRIL EQQNSSRTLE KNKKKGKIF (129-437 aa encoded by BC025987)
靶标信息
This gene encodes a member of the Jumonji, AT-rich interactive domain 1 (JARID1) histone demethylase protein family. The encoded protein plays a role in gene regulation through the histone code by specifically demethylating lysine 4 of histone H3. The encoded protein interacts with many other proteins, including retinoblastoma protein, and is implicated in the transcriptional regulation of Hox genes and cytokines. This gene may play a role in tumor progression.
仅用于科研。不用于诊断过程。未经明确授权不得转售。
生物信息学
蛋白别名: 7-Sep; CDC10 (cell division cycle 10, S. cerevisiae, homolog); CDC10 (cell division cycle 10, S.cerevisiae, homolog); CDC10 homolog; CDC10 protein homolog; cell division cycle 10 homolog; Septin-7; unnamed protein product
基因别名: CDC10; CDC3; E430034N22; NBLA02942; SEPT7; SEPT7A; Septin-7; SEPTIN7
UniProt ID: (Human) Q16181, (Mouse) O55131, (Rat) Q9WVC0
Entrez Gene ID: (Human) 989, (Mouse) 235072, (Rat) 64551